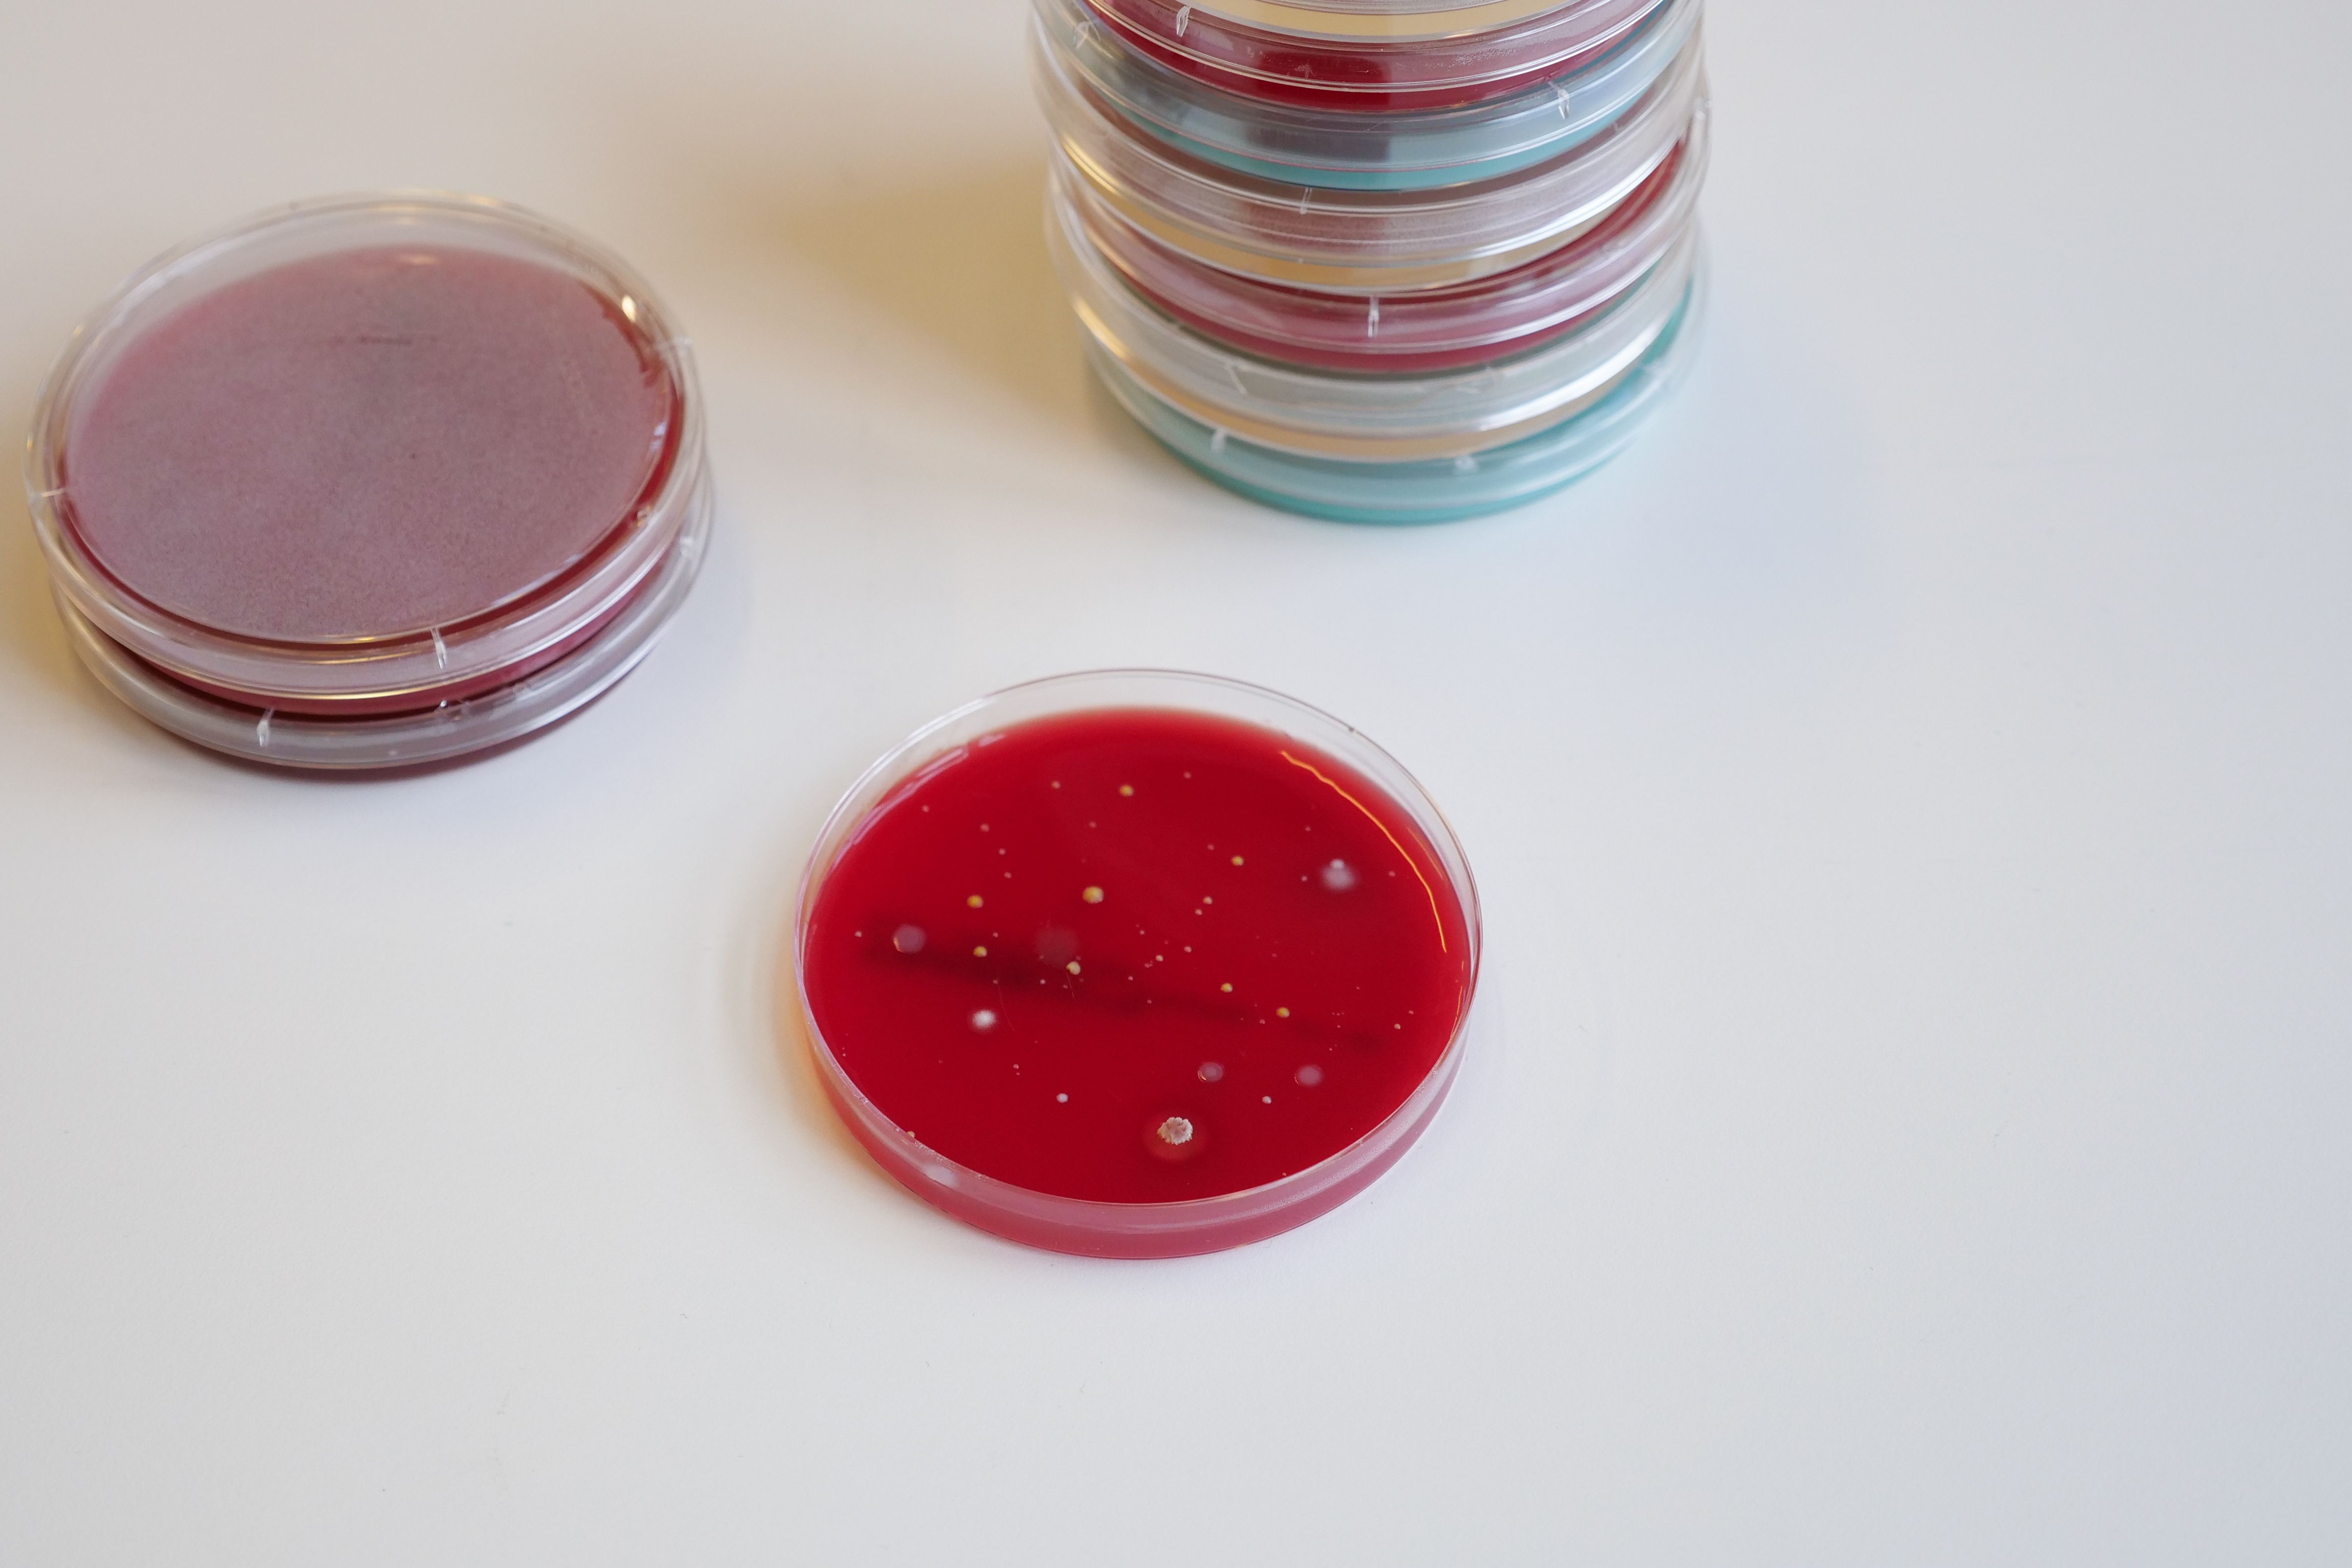
Bakterier på petriskål

Hvordan sikres kvaliteten til norsk melk?
Norsk melk kommer fra friske dyr og holder høy kvalitet. Vanlig hvit melk er ikke tilsatt verken konserveringsmidler, søtstoffer eller smaksstoffer.
Er det rester av plantevernmidler (pesticider) i melk?
KLS-standarden (Kvalitetssystemet i landbruket) skal sikre at bøndene bruker pesticider riktig og i rette mengder på gården. Det gjennomføres regelmessig undersøkelser for å finne ut om melk og andre animalske næringsmidler inneholder pesticider og andre kjemiske forurensninger. Det er ikke påvist overskridelser av slike i norsk melk.
Er det tilsetningsstoffer i melk?
Den vanlige melken som selges i Norge, er ikke tilsatt andre stoffer, verken farger, konserveringsmidler, søtningsstoffer eller smaksstoffer.
Noen melkevarianter er imidlertid tilsatt D-vitamin, og noen varianter kan være tilsatt aroma og sukker, for eksempel sjokolademelk.
Hvordan vurderes melkens kvalitet?
Melkekvaliteten er viktig både når det gjelder smak, utseende og næringsinnhold.
Kvaliteten kan vurderes ved å måle sammensetningen av næringsstoffer, fysiske og kjemiske egenskaper og andre forhold som antall somatiske celler, antall bakterier og antall termoresistente bakterier.
God melkekvalitet kjennetegnes ved:
• god lukt, smak og utseende
• lavt innhold av uønskede mikroorganismer
• normal kjemisk sammensetning fra friske kuer
• fravær av uønskede fremmedstoffer som medisinrester og vaskemiddelrester
I tillegg må melken være egnet for industriell produksjon.
Om lag 98 % av kumelksprodusentene deltar i Kukontrollen. Melken fra alle gårdstanker analyseres hver uke og hvor god kvaliteten er i følge disse analysene avgjør hva bonden får av kvalitetsbetaling for melken. Melken klassifiseres i 4 klasser etter kvalitet: Elitemelk, 1. klasse, 2. klasse og 3.klasse. Elitemelk gir tillegg i utbetalingen, mens 2. og 3. klasse gir redusert betaling for melken.
Bonden får også betalt ekstra for melken om den har mer en 3,2 prosent protein eller mer enn 4,0 prosent fett.
Alle gårder med melkeproduksjon har minimum ett medlemsbesøk fra Kukontrollen per år. I tillegg til analysene av melka fra gårdstankene, tas det analyser av melka fra enkeltdyr 5- 6 ganger pr. år (Kukontrollen). Disse analysene legges til grunn for en målrettet og effektiv rådgiving og styring av produksjonen.
Hva er det gjennomsnittlige celletall i norsk melk?
Kvaliteten på norsk melk er veldig god og celletallet i melk fra norske kyr er blant de laveste i verden. Det lave celletallet indikerer at jurhelsa i Norge er i verdenstoppen.
Hvordan kan melkens celletall fortelle noe om melkens kvalitet?
Celletallet angir antall celler per milliliter melk. Friske dyr har stabile lave celletall, og normalt celletall i norsk melk er 10-50 000 celler per milliliter. At melken inneholder celler betyr altså ikke at kua har en infeksjon.
Hvis en ku får jurbetennelse (mastitt) eller annen infeksjon, vil celletallet naturlig nok øke. Høyt celletall viser at det foregår en reparasjonsprosess i juret. Da vil også melkens sammensetning og kvalitet endres.
Gode rutiner og analyser av celletall sørger heldigvis for at jurbetennelse oppdages tidlig, ofte før kuen selv får symptomer. Dette gjør at melk fra syke kuer ikke havner på tanken og videre til forbruker.
Kommer melk fra syke dyr på gårdstanken?
Nei, jevnlige analyser og god oppfølging på gård, hindrer at melk fra syke dyr havner på gårdstanken.
Syke dyr blir behandlet og melkes separat slik at melken deres derfor ikke havner på gårdstanken.
Norsk melk er forøvrig blant den reneste i verden med tanke på celler og bakterier, fordi bøndene har fokus på at levere melk av så høy kvalitet som mulig.